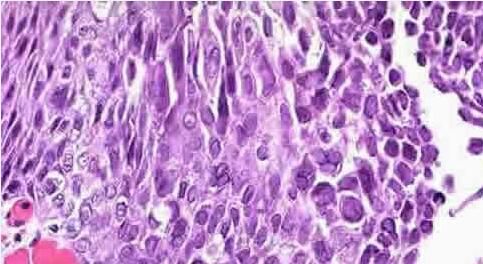

北京京城皮肤医院提供网络预约挂号服务
预约挂号热线:010-64888999
三级专科
医保定点
舒适环境
无假日
过敏性荨麻疹是常见的一种皮肤病,它经常给人带来无尽的烦恼和痛苦,因此很多人会问这个问题。给人们的生活工作带来了严重的影响,因此及时了解过敏性荨麻疹病因,可以有助于我们及早的发现以及治疗此种皮肤病。
北京京城皮肤医院指出:过敏性荨麻疹属于I型超敏反应。过敏性荨麻疹病因有,较常见的有羊肉、鱼、虾、贝壳、蟹、牛奶、蛋类等动物蛋白质,还有草莓、西红柿、大蒜等植物引起的荨麻疹。内服或注射的药物,空气中存在的霉菌孢子、花粉和化学物质被吸入,各种感染或感染性病灶的产物等。
如果您想要了解更多过敏性荨麻疹病因相关信息,可以选择挂号,您将得到满意的答复。
推荐阅读: